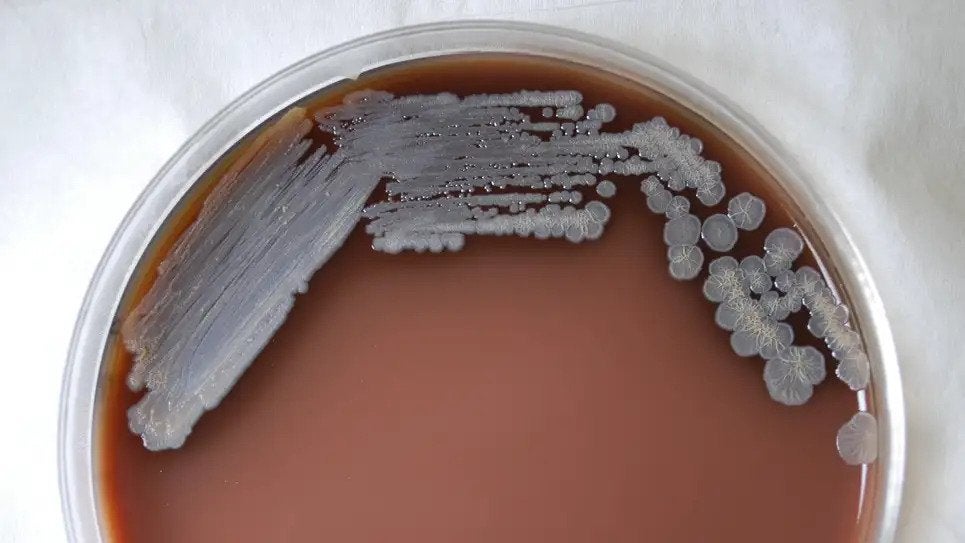
A photo of Burkholderia pseudomallei cultured in chocolate agar after three days time

Melioidosis
The infection: Melioidosis is caused by the bacteria Burkholderia pseudomallei, which is typically found in tropical and subtropical environments.
Its threat potential: Melioidosis isn’t easy to diagnose or treat. And though it’s been confined to warmer parts of the world, it can spread through imported products like contaminated aquarium water or even aromatherapy sprays. Some experts fear that climate change will allow the bacteria to find new natural reservoirs in places like the U.S.
Symptoms and treatment: Symptoms vary, depending on how people are exposed to it. In people with a respiratory infection, for instance, it can cause fever, cough, and headache. It can be treated with extensive antibiotics, but its fatality rate can be high as 50%.